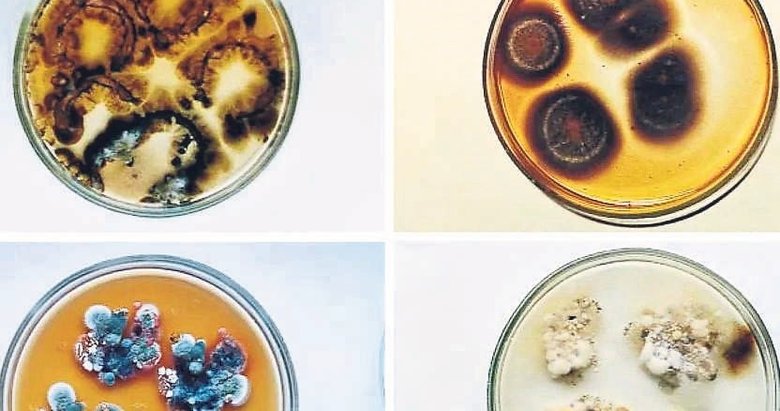
Çernobil’in siyah mantarları astronotlara kalkan olabilir

Çernobil'deki Cladosporium sphaerospermum adlı bu siyah mantarlar, 1986'daki Çernobil patlaması sonrası en tehlikeli bölgelerde bile gelişmeyi başarmıştı. İyonize radyasyonun normalde canlılar için öldürücü etkisi varken, bu mantarların tam tersine daha hızlı büyüdüğüne dair bulgular hem biyoloji hem de uzay araştırmalarında yeni bir kapı aralıyor. Bu mantarların temel özelliği, hücre duvarlarında bol miktarda bulunan melanin pigmenti. İnsanlarda UV ışınlarından korunmayı sağlayan melanin, mantarlarda daha güçlü bir zırh işlevi görüyor: Radyasyonu soğutup dağıtıyor ve bazı hipotezlere göre bu enerjiyi metabolik sürece aktarabiliyor. 2007'de bilim insanı Ekaterina Dadachova'nın yürüttüğü deneylerde, melanize mantarların radyoaktif sezyum ortamında yaklaşık %10 daha hızlı büyüdüğü tespit edilmişti. Dadachova bu olası mekanizmayı "radiosentez" (radiosynthesis) olarak adlandırmıştı.
HIZLI BÜYÜYOR
Çernobil verilerinin ardından uzaydan gelen sonuçlar da dikkat çekici. 2018'de Uluslararası Uzay İstasyonu'na gönderilen mantar örneklerinin, Dünya'daki kontrol grubuna göre yaklaşık yüzde 21 daha hızlı büyüdüğü gözlendi. Mikro yerçekimi ile kozmik ışınların etkisi hâlâ araştırılıyor; ancak ISS'de yapılan ölçümlerde, ince bir mantar tabakasının bile radyasyonu kısmen engelleyebildiği kaydedildi. Uzay görevlerinin en büyük problemlerinden biri, astronotların sürekli kozmik radyasyona maruz kalması. Su ve ağır metaller gibi klasik koruyucu materyaller etkili olsa da uzaya taşınmaları son derece maliyetli. Bu nedenle NASA'daki bazı araştırmacılar, mantarlardan üretilen hafif ve kendi kendini yenileyebilen biyolojik duvarların geleceğin yaşam alanlarında kullanılabileceğini öne sürüyor. Eğer melanin temelli radyasyon emilimi uzay ortamında da doğrulanırsa, bu yapılar düşük maliyetli ve sürdürülebilir bir koruma sistemi olarak değerlendirilebilir.
HENÜZ TEMKİNLİ
Yine de bilim insanları temkinli. Radiotropism ve radiosentez gibi kavramlar bilim dünyasında hâlâ tartışmalı. Bazı çalışmalarda melanize mantarların radyasyona yönelmediği veya büyüme hızlarında anlamlı artış olmadığı da raporlandı. Buna rağmen şimdiye kadar elde edilen veriler, bu organizmaların ekstrem koşullara uyum sağlama yeteneğinin olağanüstü olduğunu açık biçimde gösteriyor. Çernobil'in ölümcül enkazında ortaya çıkan bu siyah mantarlar, bir zamanlar nükleer felaketin simgesi olarak görülüyordu. Ancak ironik bir şekilde, ileride insanlığı başka bir ölümcül ortamdan—uzayın yoğun radyasyonundan koruyabilecek biyolojik bir teknolojiye dönüşebilirler. Belki de insanlığın başka gezegenlerde kuracağı yaşam alanlarının güvenliği, bu karanlık mantarlara dayanacak.